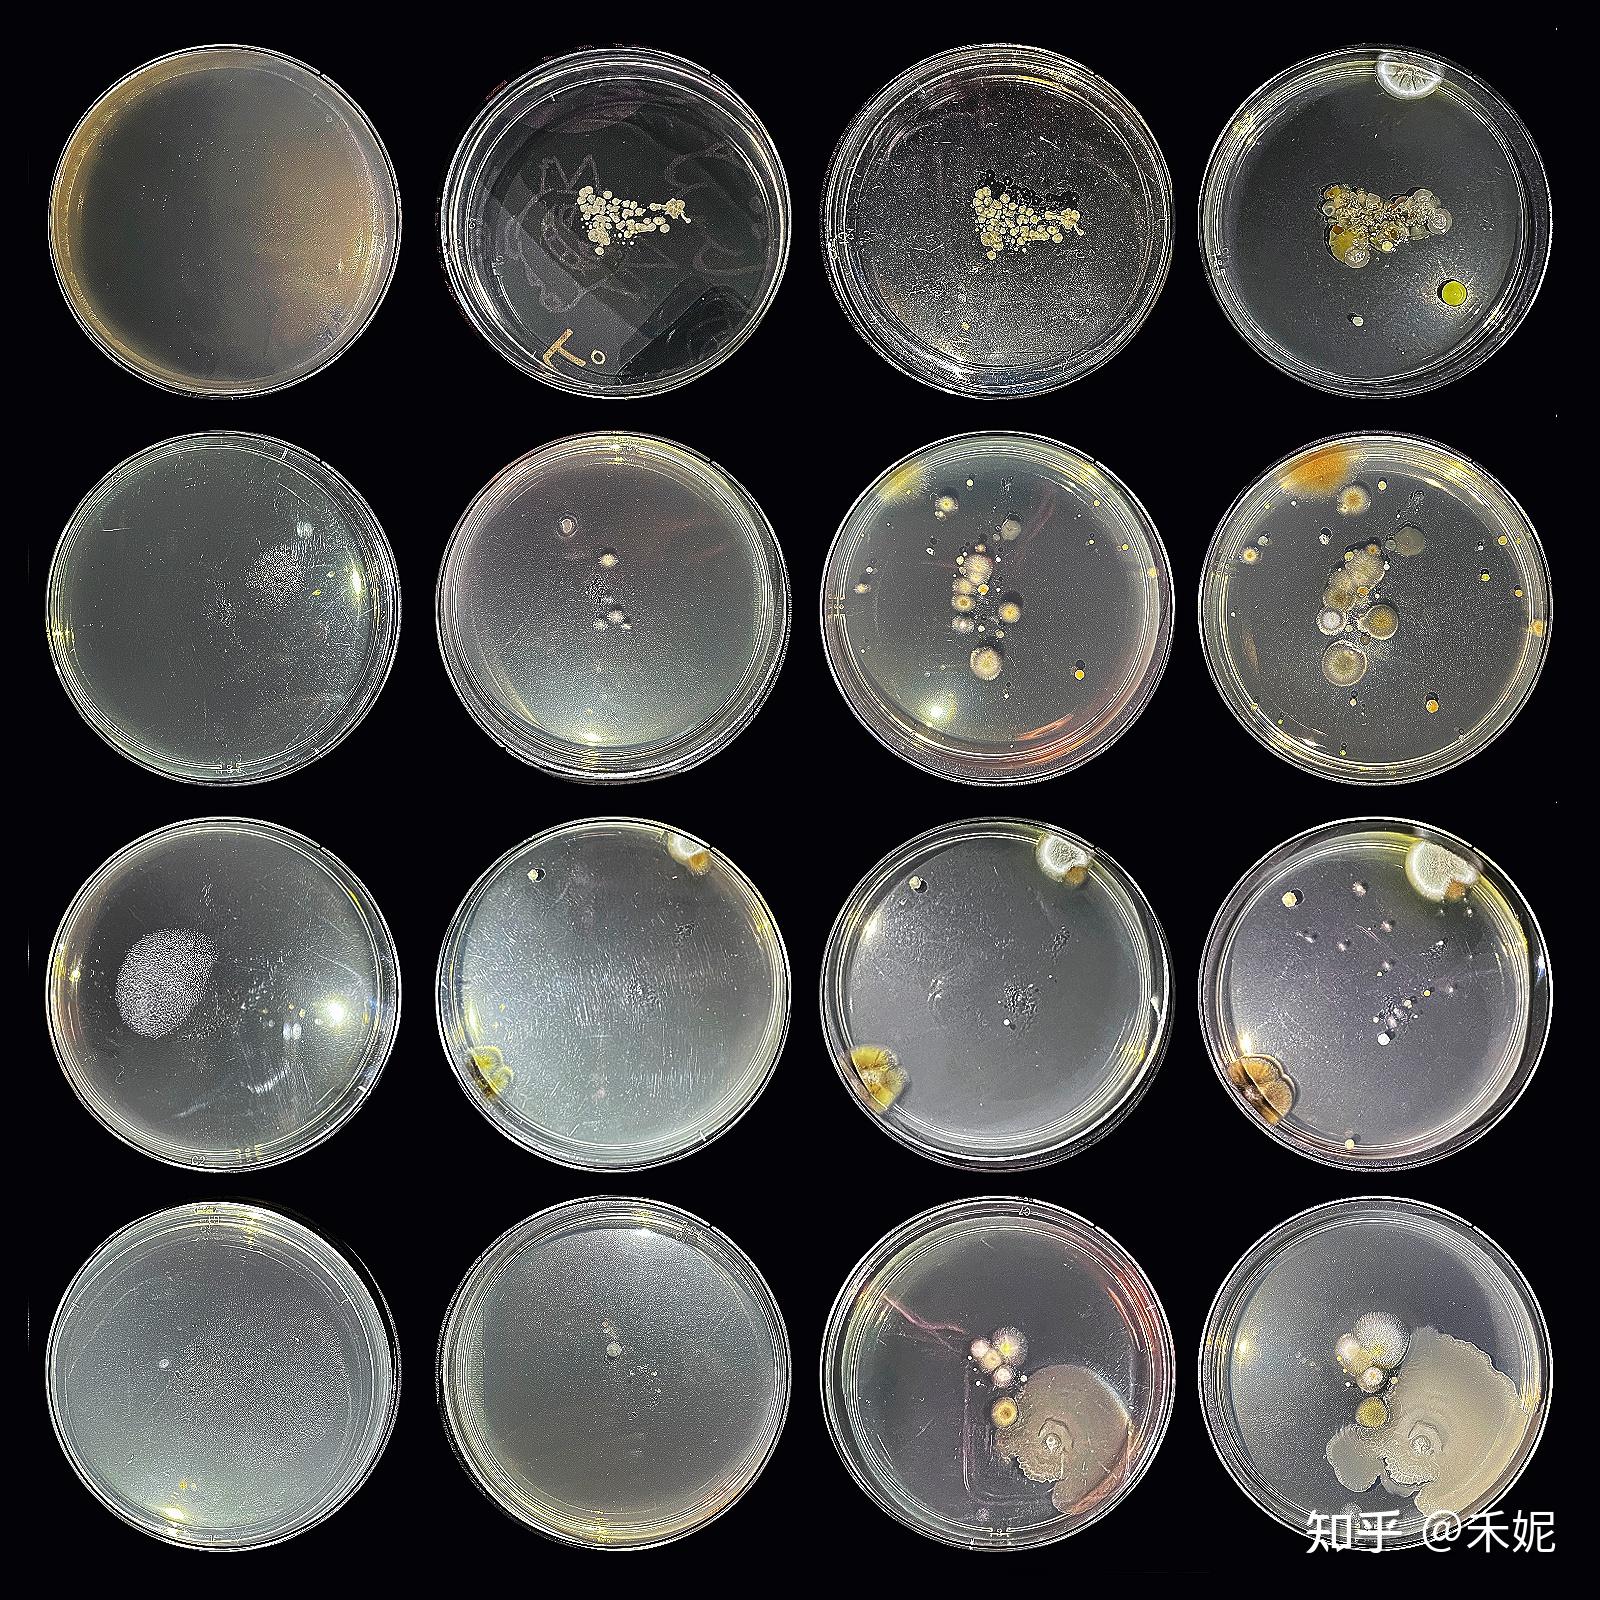
菌群生长可视化

培养皿菌群

皮氏培养皿,大群动物,细菌,背景,个性
图片尺寸1200x800
菌群生长可视化
图片尺寸1600x1600
请问各位大神这培养皿里面各是什么菌呢?
图片尺寸2448x3264
培养皿上的细菌菌落
图片尺寸1162x1100
鲁氏耶尔森氏菌在胰蛋白胨大豆琼脂培养皿(tsa)或脑心浸液琼脂培养皿
图片尺寸1080x810
不同的细菌和霉菌菌落生长在有营养琼脂的培养皿上
图片尺寸1200x795
培养皿中一个大肠杆菌菌落是由一个大肠杆菌分裂形成的菌群
图片尺寸737x543
大肠杆菌和大肠菌群显色培养基.jpg
图片尺寸2288x1712
透射电子显微镜下培养皿中的克雷伯氏菌.
图片尺寸600x451
培养皿细菌培养实验菌群 (2)
图片尺寸712x400
培养皿中的真菌菌落,样品全部来源于土壤
图片尺寸516x378
2.1.4 凡系革兰氏阴性无芽孢杆菌,再接种乳糖蛋白胨培养液,经36
图片尺寸1503x1000
培养皿培养板显示由羊血琼脂生长培养基产生的类鼻疽菌落生长
图片尺寸600x318
手拿一个有细菌的培养皿
图片尺寸1200x800
大家帮我看看培养皿是什么菌啊
图片尺寸2560x1920
送学校"会长大"的生日礼物|细菌|沙雷氏|培养基|培养皿_网易订阅
图片尺寸660x268
培养皿中的泄殖腔肠杆菌菌落.(图片来源: cdc)
图片尺寸623x580
有盖培养皿,里面有生长中的细菌
图片尺寸1100x1100
培养皿中培养的耳念珠菌菌株(来源:视觉中国)
图片尺寸1000x997
不同的细菌和霉菌菌落生长在有营养琼脂的培养皿上
图片尺寸1200x795